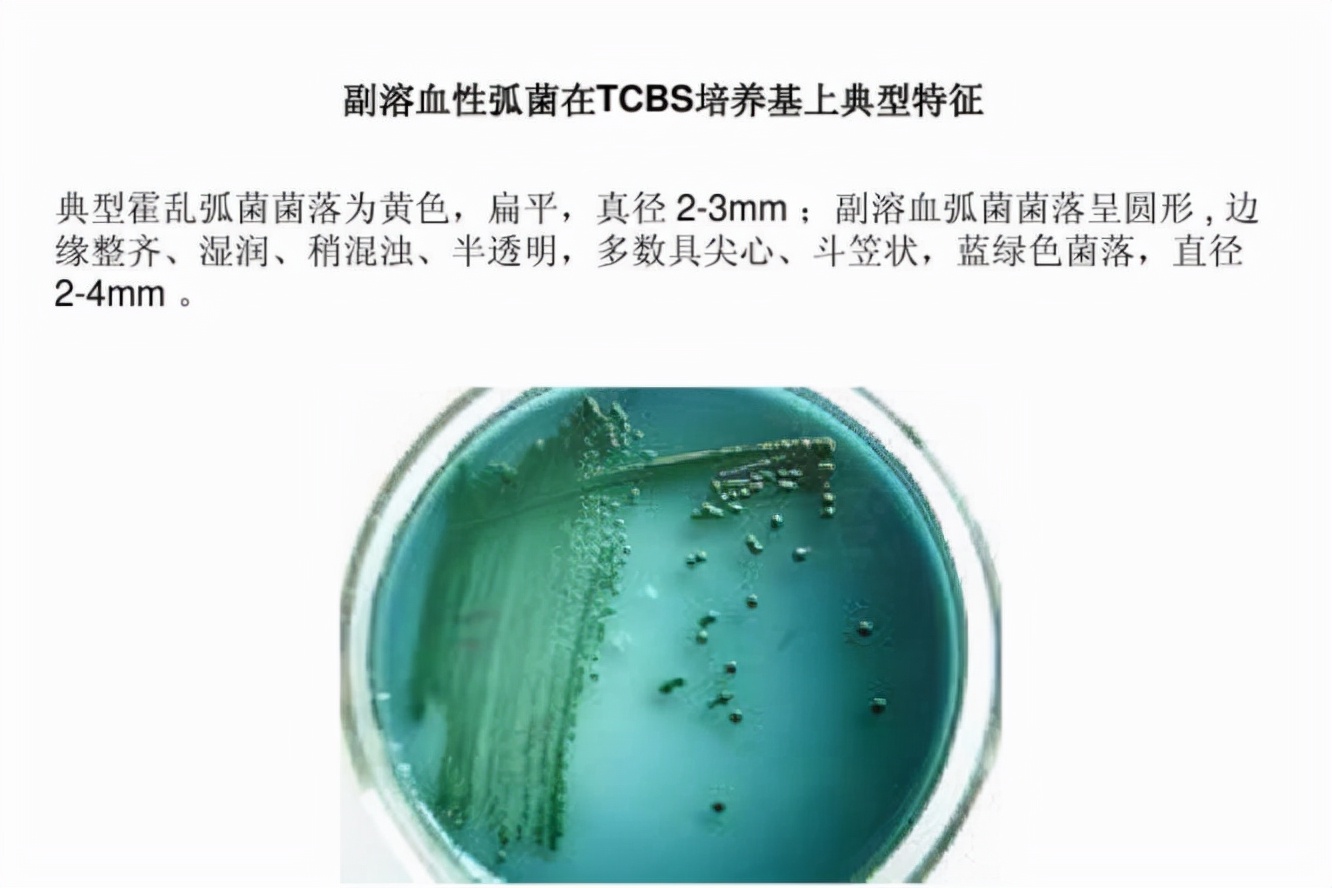
食源性过敏原,食源性致病菌引发的国际案例

最近,新闻上频频出现“某男子连续食用过期食物导致住院”等和食物相关的热点。古今中外,食品都是人类生命活动的基础。现如今,人民生活富足,不再像以前只追求量,其质是更为重要的,与此同时,人类的肠胃环境也悄悄发生了一些变化,为了适应现在的饮食习惯和节奏。
“ 食源性疾病 ,是指有毒有害物质(包括生物性病原体)通过食物途径进入人体所造成的疾病。而其首要因素就是致病菌,由其污染而引起的食源性疾病危害远远超过违法滥用添加剂、农药残留等食品化学性污染,是食品安全的重大隐患,也是食品安全的重要问题之一。”
“ 食源性致病菌 (foodborne pathogen)是指以食物为载体而导致人类发生疾病的一大类细菌。包括大肠杆菌、沙门氏菌、金黄色葡萄球菌、单核细胞增生李斯特氏菌、志贺氏菌等。目前由食源性致病菌引起中毒的报告起数和中毒人数一直占很高比例。”
我国的食品微生物污染事件频发,最常见的5种致病细菌是:沙门氏菌、金黄色葡萄球菌、副溶血性弧菌、阪崎肠杆菌、单核细胞增生李斯特氏菌,污染食品且符合我国国情和地域饮食特点。这些肉眼难以捕捉的微生物,只能靠专业设备才能检测出来。平时民众只能防患于未然,做好食品安全的日常基础工作。牢记“保持清洁、生熟严分、荤食熟透、及时冷藏、拒绝过期”。
一、 沙门氏菌 (需氧及兼性厌氧菌)

食源性致病菌,原来是你在捣乱
沙门氏菌是一种常见的食源性致病菌,革兰氏阴性肠道杆菌,属肠道细菌科,包括那些引起食物中毒,导致胃肠炎、伤寒和副伤寒的细菌。1885年沙门氏等在霍乱流行时分离到猪霍乱沙门氏菌,故定名为沙门氏菌属。沙门氏菌感染症为人畜共患感染性疾病,主要由食用遭受污染的食物导致,是许多国家食物中毒的重要病源。该菌主要污染肉类食品,鱼、禽、奶、蛋类食品也可受此菌污染。沙门氏菌食物中毒全年都可发生,吃了未煮透的病、死牲畜肉或在屠宰后其他环节污染的牲畜肉是引起沙门氏菌食物中毒的最主要原因。有食品专家指出美国人吃鸡蛋的习惯与国人不同,他们喜欢吃半熟的鸡蛋甚至是生鸡蛋,所以一旦鸡蛋里含有沙门氏菌,感染的几率就比较高。据统计,在世界各国的种类细菌性食物中毒中,沙门氏菌引起的食物中毒常列榜首。
由沙门氏菌引起的食品中毒症状主要有恶心、呕吐、腹痛、头痛、畏寒和腹泻等,还伴有乏力、肌肉酸痛、视觉模糊、中等程度发热、躁动不安和嗜睡,持续时间2~3天,通常在发热后72小时内会好转。婴儿、老年人、免疫功能低下的患者则可能因沙门氏菌进入血液而出现严重且危及生命的菌血症,少数还会合并脑膜炎或骨髓炎,平均致死率为4.1%。沙门氏菌在水中不易繁殖,但可生存2-3周,冰箱中可生存3-4个月,在自然环境的粪便中可存活1-2个月。沙门氏菌最适繁殖温度为37℃,在20℃以上即能大量繁殖,因此,低温储存食品是一项重要预防措施。
我国国家卫生和计划生育委员会于2013年发布了《食品安全国家标准 食品中致病菌限量》(GB 29921-2013),在国标中分别对肉制品、水产制品、即食蛋制品、粮食制品、饮料、冷冻饮品、即食调味品等11类产品规定了沙门氏菌的限量要求,均为不得检出。
二、 金黄色葡萄球菌 (需氧菌)

食源性致病菌,原来是你在捣乱
金黄色葡萄球菌(以下简称“金葡菌”),隶属于葡萄球菌属,是革兰氏阳性菌代表,为一种常见的食源性致病微生物,广泛存在于空气、水、灰尘及人和动物的排泄物中。它是一种人兽共患病原菌,可导致人和动物的多种疾病,包括伪膜性肠炎、败血症和脓毒症等,严重威胁人类和动物的生命安全。该菌最适宜生长温度为37℃,pH为7.4,耐高盐,可在盐浓度接近10%的环境中生长。金葡菌常寄生于人和动物的皮肤、鼻腔、咽喉、肠胃、痈、化脓疮口中,空气、污水等环境中也无处不在。
金葡菌广泛存在于自然环境中。在适当的条件下,能够产生肠毒素,引起食物中毒。近几年,由其引发的食物中毒报道层出不穷,占食源性微生物食物中毒事件的 25%左右,已成为仅次于沙门氏菌和副溶血性弧菌的第三大微生物致病菌。
《食品安全国家标准 食品中致病菌限量》(GB 29921-2013)制定了金葡菌的限量标准,规定熟肉制品、熟制水产品、熟制粮食制品等8大类食品中,同批次采集5份样品,每份样品中的金葡菌浓度均不得超出1000 CFU/g,仅允许其中1份样品在100~1000 CFU/g之间。
三、 副溶血性弧菌 (兼性厌氧菌)
食源性致病菌,原来是你在捣乱 www.czprolab.com/news/4.html
副溶血性弧菌呈弧状、杆状、丝状等多种形状,无芽孢,是一种嗜盐性细菌,是革兰氏阴性杆菌。主要来源于海产品,如墨鱼、海鱼、海虾、海蟹、海蜇,以及含盐分较高的腌制食品,如咸菜、腌肉等。其存活能力强,在抹布和砧板上能生存1个月以上,海水中可存活47天。此菌对酸敏感,在普通食醋中5分钟即可杀死,对热的抵抗力也较弱。
副溶血性弧菌食物中毒原因主要是烹调时未烧熟煮透或熟制品被污染。人们食用被副溶血性弧菌污染的食物后极可能会引起以腹痛(在脐部附近剧烈,多为阵发性绞痛)、腹泻、恶心、呕吐、发热等为主要症状的急性肠胃炎。潜伏期2~24小时,一般为10小时发病。其特征之一为中毒者的粪便多呈水样,且常混有粘液或脓血。此外,重症患者还可出现脱水、休克昏迷,少数病人可出现意识不清、痉挛、面色苍白或发绀等现象,若抢救不及时,呈虚脱状态,甚至可导致死亡,故副溶血性弧菌又有肠炎弧菌之称。
在《食品安全国家标准 食品中致病菌限量》(GB 29921-2013)中制定了副溶血性弧菌的限量标准,规定水产制品、即食调味品中,同批次采集 5 份样品,每份样品中的副溶血性弧菌浓度均不得超出1000 MPN/g,仅允许其中1份样品在100~1000 MPN/g之间。
四、 阪崎肠杆菌 (兼性厌氧菌)

食源性致病菌,原来是你在捣乱 www.czprolab.com/news/4.html
阪崎肠杆菌又叫黄色阴沟肠杆菌,直到1980年才被认为是一个新的菌种,并以日本微生物学家——Riichi Sakazakii的名字命名。它是一种周生鞭毛,能运动,比较常见的寄生在人和动物肠道内的无芽孢棒状杆菌、革兰氏阴性菌,其在一定的条件下可以使人或动物致病,因而被称为条件致病菌。生长温度为0~45 ℃,生长pH范围5~10。
由于阪崎肠杆菌具有一定的耐热、耐干燥性,而且细胞外部有一层便于吸附于物体表面的特殊生物膜,使得该菌分布较为广泛,现已从奶粉(乳)制品、牛肉馅、香肠、干酪、蔬菜、谷物类、豆腐、莴苣、药草和调味料等分离出了该菌。
阪崎肠杆菌是一种食源性的条件致病菌,主要危害对象是免疫力低下的新生儿,由其引发的婴儿、早产儿脑膜炎、败血症及坏死性结肠炎散发和暴发的病例已在全球相继出现,死亡率高达50% 以上。奶粉中的阪崎肠杆菌和沙门氏菌等是导致婴幼儿感染、疾病和死亡的主要原因。
五、 单核细胞增生李斯特氏菌 (兼性厌氧菌)

食源性致病菌,原来是你在捣乱 www.czprolab.com/news/4.html
单核细胞增生李斯特氏菌(以下简称单增李斯特菌)是由一位名叫“约瑟夫·李斯特”的外国医生发现的。主要特征之一是可在低温下生长,0~45℃都能生存,在零下20℃的环境下仍能存活1年,在冰箱冷藏室4~6℃的温度下仍可大量繁殖,所以就有“冰箱杀手”的称号。
它在自然界分布非常广泛,土壤、粪便、水体、蔬菜、青贮饲料以及多种食品中都存在。单增李斯特菌属于细胞内寄生致病菌,它自身不产生内毒素,而是产生一种具有溶血性质的外毒素——单增李斯特菌溶血素O(LLO),是其重要毒力因子。最容易污染的食品为乳和乳制品、肉和肉制品、蔬菜、沙拉、海产品和冰淇淋等,尤其是冰箱中保存时间过长的乳制品、肉制品最为常见。
由于体液免疫对单增李斯特菌感染无保护作用,故细胞免疫力低下和使用免疫*制剂抑**的患者容易受到它的感染。感染后的临床症状表现为:轻者为腹泻、腹痛、发热;重者可导致败血症、脑膜炎和脑脊膜炎,孕妇可出现流产、死胎等后果,幸存的婴儿则易患脑膜炎导致智力缺陷或死亡。
2010年发布的乳制品安全标准及国家标准《食品安全国家标准 食品中致病菌限量》(GB 29921-2013)分别对干酪、再制干酪、熟肉制品以及即食生肉制品规定了单增李斯特菌的限量要求,均为不得检出。